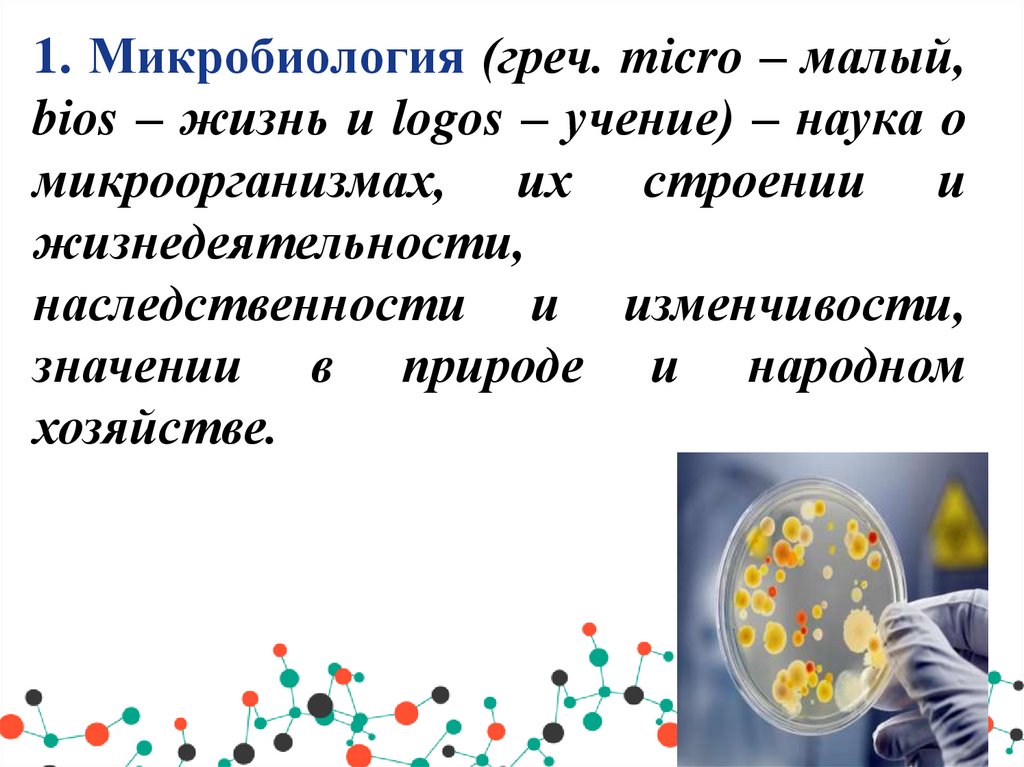
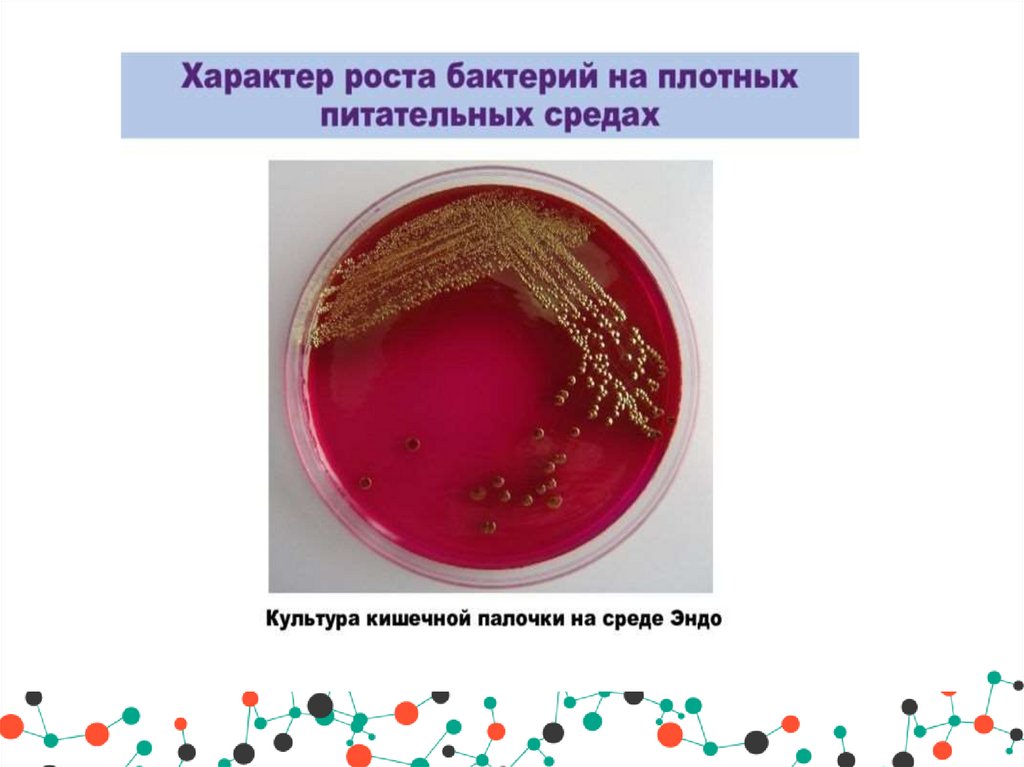

Похожие презентации:
Общая микробиология, вирусология, иммунология. Морфология, физиология и распространение микроорганизмов. Введение
1.
Тема занятия: Введение.Раздел I. Общая микробиология,
вирусология, иммунология.
Морфология, физиология и
распространение микроорганизмов
Подготовила преподаватель:
Рудик Т.В.
2. План занятия:
• 1.Микробиология как наука, изучающая закономерности жизни иразвития микроорганизмов.
• 2.Цели и задачи учебного предмета «Микробиология, вирусология,
иммунология».
• 3.Основные этапы исторического развития микробиологии,
основоположники микробиологии.
• 4.Связь с другими учебными предметами (модулями), значение в
формировании профессиональных компетенций медицинской сестры
(медицинского брата).
• 5.Развитие микробиологии, вирусологии и иммунологии в
Республике Беларусь.
• 6.Принципы и подходы к классификации микроорганизмов,
определение терминов «вид», «род», «штамм», «клон», «чистая
культура».
• 7.Различия в организации клеток прокариот и эукариот, основные
отличия вирусов, размеры и основные формы бактерий.
• 8.Физиология микроорганизмов, рост, питание и дыхание
микроорганизмов.
3.
1. Микробиология (греч. micro – малый,bios – жизнь и logos – учение) – наука о
микроорганизмах, их строении и
жизнедеятельности,
наследственности и изменчивости,
значении в природе и народном
хозяйстве.
4. Объектом изучения микробиологии являются микроорганизмы (размеры в пределах 0,2 - 20 мкм (чаще 0,5- 10 мкм) : 1) простейшие; 2)
одноклеточные водоросли;3) микроскопические грибы;
4) бактерии;
5) вирусы.
5. Основные разделы микробиологии: 1)общая; 2)техническая(промышленная); 3)ветеринарная; 4) санитарная; 5) радиационная и
космическая;6) медицинская.
,
6. Общая микробиология изучает систематику, структурную организацию, химический состав, ферментные системы, культивирование и
генетикумикроорганизмов.
Техническая (промышленная) микробиология изучает микроорганизмы,
которые используют в производстве пищевых продуктов, антибиотиков,
ферментов, витаминов, стероидов, аминокислот и прочих биологически
активных веществ, молочных и других продуктов, чая, кофе, какао,
обработке каучука, хлопка, шелка, дублении кож и др.
Ветеринарная микробиология изучает микроорганизмы, вызывающие
заболевания животных, разрабатывает методы их биологической
диагностики, специфической профилактики и этиотропного лечения,
направленного на уничтожение микробов-возбудителей в организме
больного животного.
Санитарная микробиология изучает микробную обсемененность
окружающей среды, в частности выживаемость на различных объектах
санитарно-показательных и патогенных микробов, их влияние на здоровье
человека и естественные процессы.
Радиационная и космическая микробиология изучает влияние
ионизирующих излучений и космических частиц на микроорганизмы.
7.
Медицинскаямикробиология
Общая
рассматривает свойства
микроорганизмов и их
взаимодействие с
организмом хозяина
изучает микроорганизмы,
вызывающие заболевания
человека, и процессы,
происходящие в организме
при внедрении
болезнетворных
микроорганизмов.
Частная
характеризует возбудителей
отдельных заболеваний и методы
их лабораторной диагностики.
8.
В настоящее время из медицинской микробиологиивыделены:
- вирусология (наука о вирусах);
- протозоология (изучает простейшие);
- микология (изучает грибы);
- иммунология (рассматривает защитные процессы,
происходящие в организме);
- санитарная микробиология (занимается
микроорганизмами, обитающими во внешней
среде);
- космическая микробиология (изучает влияние
космических условий на микроорганизмы и
изменение микробной флоры человека в космосе).
9. 2. Задачи медицинской микробиологии:
• - изучение структуры и микробиологических свойствмикробов;
• - изучение взаимоотношения микробов с организмом
человека (т.е. инфекции), а именно:
- патогенеза;
- диагностики;
- лечения;
- профилактики.
NB ! Главная задача медицинской
микробиологии – ликвидация инфекционных
заболеваний.
10. 3. Основные этапы исторического развития микробиологии, основоположники микробиологии.
Этапы развития микробиологии :• эвристический,
• морфологический,
• физиологический,
• иммунологический
• молекулярно-генетический.
11. Эвристический период (IV - III вв. до н.э. - XVI в.) связан скорее с логическими и методическими приемами нахождения истины, то
есть эвристикой( мыслительные приемы), чем скакими-либо экспериментами и доказательствами.
• В трудах учеными Древней Греции Гиппократом (460-377 до н.
э.), Лукрецием (95-55), Галеном (131-211 до н.э.) была
высказана гипотеза о живой природе возбудителя заразных
заболеваний.
• Римский писатель Варрон, Авиценна и др. высказывали
предположения о природе заразных болезней, миазмах,
мелких невидимых животных. Эти представления были
сформулированы спустя многие столетия в сочинениях
итальянского ученого Джироламо Фракасторо (1478 - 1553
гг.). Он написал свой знаменитый труд «О контагии,
контагиозных болезнях и лечении»(1546) в трех книгах. В
труде изложены основы учения о «контагии» -живом,
размножающемся начале, который выделяется больным
организмом. Для предохранения от болезней им были
рекомендованы изоляция больного, карантин, ношение
масок, обработка предметов уксусом.
12. Морфологический период - конец XVII – cер. XIX в.в. Открытие мира микроорганизмов, описание их внешнего вида
13. Физиологический (пастеровский) период вторая половина XIX в. изучение жизнедеятельности микробной клетки, открытие
болезнетворных бактерий, начало научной микробиологииВ этот период были установлены возбудители:
фавуса (парши) - И. Шенлейн, 1839,
стригущего лишая - И. Груби, 1843,
в крови больных животных обнаружены бациллы
сибирской язвы - А. Полендер,1849; К. Давен,1850,
туберкулеза - Роберт Кох, 1882.
14. Роберт Кох(11 декабря 1843 — 27 мая 1910) - немецкий врач, микробиолог и гигиенист.
Роберт Кох(11 декабря 1843 — 27 мая 1910) немецкий врач, микробиолог и гигиенист.- предложил использовать для
микроскопирования бактерий
иммерсионную систему,
- для выращивания микробов плотные питательные среды на
основе желатина и агара,
- разработал методы выделения
чистых культур микроорганизмов и
методы окраски микробов
анилиновыми красителями
(метилфиолетовым и фуксином),
- обосновал использование
дезинфектантов при инфекционных
заболеваниях.
15. Луи Пастер (1822 – 1895) -основоположник микробиологии как науки
• - внес большой вклад в развитиенауки об иммунитете и микробов,
- создал ряд предупредительных
прививок,
- создал и применил первую вакцину
от сибирской язвы и бешенства,
- открыл природу брожения,
- предложил метод прогревания
пищевых продуктов для
уничтожения патогенных микробов
без вреда для продуктов
(пастеризация, 1865),
- предложил метод автоклавирования
– прогревания изделий до 120
градусов в паровом котле.
16.
- нач. – cер. XX в.17.
18. Молекулярно-генетический период (с 50-х гг. ХХ в.по наст. время)
Львов – открытие провируса;Портер и Эдельман – открытие структуры
антител;
Бернет – клонально-селекционная теория
иммунитета;
Галло и Монтанье – открытие ВИЧ;
Пруссинер – открытие
прионов
расшифрован генетический код человека,
открыты биологически активные
вещества.
19. 4.Связь с другими учебными предметами (модулями), значение в формировании профессиональных компетенций медицинской сестры
(медицинского брата).Учебный предмет «Микробиология, вирусология,
иммунология» тесно связан с такими учебными предметами,
как «Анатомия и физиология», «Сестринское дело и
манипуляционная техника», «Фармакология», «Латинский язык
и медицинская терминология», «Гигиена и экология человека».
Задачи, стоящие перед учащимся, по изучению материала
микробиологии:
• Изучить биологию, классификацию, экологию паразитов
человека, влияние их на организм человека, изучить
структуру и функции иммунной системы человека.
• Получить представление о работе микробиологической
лаборатории, о лабораторной диагностике инфекционных
болезней.
• Изучить назначение и применение иммунобиологических
препаратов.
20. Развитие микробиологии в Беларуси
Жилибер – конец XVIII в.- впервые на территории Беларуси (в г.
Гродно) применил микроскоп для
диагностики болезни человека
Эльберт – 20-е – 60-е гг. XX в.
- основатель первой в Беларуси кафедры
микробиологии ( г. Минск);
- работы по клебсиеллам;
- вакцина против туляремии
Гельберг – 20-е – 80-е гг. XX в.
- основатель кафедры микробиологии
Гродненского мединститута;
- работы по микобактериям
Красильников – 40-е – 90-е гг. XX в.
- ведущий белорусский бактериолог конца
XX в.;
- работы по лептоспирам;
- работы по клебсиеллам
21. 4. Систематика и таксономия МО Характеристика основных таксонов
Различают следующие таксономические категории: царство,подцарство, отдел (тип), класс, порядок, семейство, род, вид,
подвид.
Систематика микроорганизмов – специальная наука,
занимающаяся систематизацией микробов по их сходству,
различиям и взаимоотношениям между собой.
Таксономия – раздел систематики, разрабатывающий
принципы
классификации.
В
основу
таксономии
микроорганизмов
положены
их
морфологические,
физиологические,
биохимические
и
молекулярнобиологические свойства.
22. Характеристика основных таксонов
Таксон – группа микроорганизмов, объединенных по схожимсвойствам (морфологическим, физиологическим признакам).
Таксон выделяется в рамках той или иной таксономической
категории.
Вид - это совокупность происходящей от одного предка
скрещивающейся
популяции,
обладающей
общим
генофондом, экологическим единством и репродуктивной
изоляцией, т.е. между особями одного вида происходит
свободный обмен генами, а между особями разных видов
обмен или невозможен или затруднен. Вид является основной
таксономической единицей.
Подвид – географически или экологически обособленные
популяции, в которых все или большинство особей
отличаются одним или несколькими признаками от особей
других популяций того же вида.
23. Характеристика основных таксонов
Род - это группа микроорганизмов с определенными общимисвойствами.
Семейство - группа родов, имеющих общие определяющие
свойства.
Штамм – культура, выделенная из определенного источника
(окружающая среда, патологический материал человека и
животных, музей биологических препаратов), или из одного и
того же источника в разное время.
Клон – культура микроорганизма, выделенная из одной
клетки (одноклеточная структура).
Чистая культура – микробные особи одного и того же вида,
выращенные из изолированной колонии, выращенной на
твердой питательной среде.
24.
Бинарная номенклатура (К.Линнеей)кроме вирусов
Staphylococcus aureus - стафилококк золотистый.
обозначает род
и пишется с
заглавной
буквы
Порядки и семейства
обозначает вид и пишутся тоже прописными
пишется со
буквами с окончаниями –
строчной буквы
ales (порядок) и – ceae
(семейство): Ricettsiales и
Ricettsiaceae
В названиях могут быть отражены имена исследователей,
открывших микроорганизмы: бруцеллы - в честь Брюса,
эшерихии - в честь Эшериха и т. д. В ряд наименований
включены органы, которые поражает данный микроорганизм:
пневмококки - легкие, менингококки - мозговую оболочку и т.
д.
25.
26.
27. Объекты изучения МИКРОБИОЛОГИИ
Живые организмы1. Прокариоты:
- бактерии,
(микроорганизмы)
- риккетсии,
- хламидии,
- микоплазмы.
2. Низшие эукариоты:
- Паразитические Грибки и Простейшие
3. Неклеточные формы жизни:
Вирусы Прионы Плазмиды
28. Общая организация и размножение микробов
Прокариоты- Подобие ядра (нуклеоид);
- Нет внутриклеточных систем
элементарных мембран и
митохондрий;
- Некоторые лишены
клеточной стенки;
- Размножение: простое
поперечное деление или
почкование
Эукариоты:
- Ядро;
- Есть внутриклеточные системы
элементарных мембран и
митохондрий;
- Рибосомы, включения;
- Клеточная стенка имеет разный
характер строения;
Размножение: половое и
бесполовое
Вирусы:
- Неклеточная структура;
- Генетические паразиты;
Размножение:
репродукция
с
помощью
энергообменных систем клетки-хозяина.
29.
Основные отличия прокариотов и эукариотовКомпоненты клеток
Постоянные
Непостоянные
Прокариот
Нуклеоид (подобие ядра)
Клеточная стенка
Цитоплазма
Рибосома 70S
Мезосомы
ЦПМ
(цитоплазматическая
мембрана)
Жгутики
Пили (ворсинки)
Плазмиды
(внехромосомные
)
Капсула
Споры
Включения
Эукариот
Ядро
Клеточная оболочка
Цитоплазма
Рибосома 80S
Митохондрии
ЦПМ
Аппарат ЭПС
Центриоли
Вакуоли
Жгутики
Включения
30.
5. Классификация бактерий с учетом особенностиклеточной стенки и отношению к окраске по методу
Грама ( Д. Берджи)
1 группа: бактерии с тонкой клеточной стенкой, т.е. Гр(окрашивание в розовый цвет) - Грациликуты;
2 группа: бактерии с толстой стенкой, т.е. Гр+ (окрашивание в
фиолетовый цвет) - Фирмикуты;
3 группа: бактерии, лишенные клеточные стенки –
Тенерикуты;
4 группа: бактерии с дефектной клеточной стенкой (патогенных
нет) – Мендозикуты.
31.
Гр+ и Гр- бактерииХанс Христиан Грам (1853 – 1939 гг.). Предложил метод
окаршивания бактерий. Окраска по Граму делит бактерии на
основе структуры их клеточной стенки на две группы: Гр+
прочно удерживают анилиновые красители, не обесцвечиватся при
обработке спиртом, окрашиваются в синий цвет. Гробесцвечиваются
спиртом
и
поэтому
дополнительно
докрашиваются фуксином (красный цвет).
Гр+ бактерии имеют толстую клеточную стенку, которая состоит
из 5-6 слоев пептидогликана, связаных с тейхоевыми и
липотейхоевыми кислотами, которые берут своё начало от ЦПМ
(цитоплазматическая мембрана).
Гр- бактерии имеют тонкую клеточную стенку, в ней выделяют
два
слоя.
1-ый
слой
пластичный
представлен
липополисахаридами, фосфолипидами, белками; 2-ой слой
ригидный образован 1-2 слоями пептидогликана. Синоним –
эндотоксин.
32.
33. Бактерии
Бактерии - это одноклеточные организмы, лишенныехлорофилла.
Средние размеры бактериальной клетки - 2-6 мкм. Размеры и
форма клеток бактерий, присущие микроорганизмам
определенного вида, могут изменяться под влиянием
различных
факторов
(в
зависимости
от
возраста
бактериальной культуры, среды обитания и пр). Это явление
называется полиморфизмом.
По форме клетки бактерии делятся на три группы:
шаровидные
извитые
палочковидные
34. Шаровидные бактерии называются кокки (от лат. coccus - ягода) и имеют диаметр клетки от 0,5 до 1 мкм.
Форма кокков:сферическая, ланцетовидная, бобовидная.
Взаимное расположение клеток:
микрококки (от лат. micros - малый) - клетки делятся в
разных плоскостях и располагаются поодиночке;
диплококки (от лат. diploos - двойной) - клетки делятся в
одной плоскости и затем располагаются попарно; к ним
относятся ланцетовидные пневмококки и бобовидные
гонококки и менингококки;
стрептококки (от лат. streptos - цепочка) - клетки делятся в
одной плоскости и не расходятся, образуя цепочку;
стафилококки (от лат. staphyle - гроздь) - клетки делятся в
различных плоскостях, образуя скопления в виде грозди
винограда;
35.
Взаимное расположение клеток кокков:тетракокки (от лат. tetra - четыре) - клетки делятся в
двух взаимно перпендикулярных плоскостях и
располагаются по четыре;
сарцины (от лат. sarcio - соединяю) - клетки делятся в
трех взаимно перпендикулярных плоскостях и
располагаются в виде тюков или пакетов по 8 или 16
клеток в каждом.
Палочковидные формы называются бактериями.
Средние размеры их от 1 до 6 мкм в длину и от 0,5 до 2
мкм в толщину.
36.
37.
Бактерии различаются по внешнему виду:- концы их могут быть закругленными (кишечная
палочка),
- обрубленными (возбудитель сибирской язвы),
- заостренными (возбудитель чумы) или
утолщенными (возбудитель дифтерии).
После деления бактерии могут располагаться попарно
- диплобактерии (клебсиеллы), цепочкой (возбудитель
сибирской язвы), иногда под углом друг к другу или
крест-накрест (возбудитель дифтерии). Большинство
бактерий располагается беспорядочно.
Изогнутые формы - вибрионы
(возбудитель холеры).
Извитым формы - спириллы и
спирохеты.
38. Формы бактерий
39. 7. Строение бактериальной клетки
• Основные образования:• Дополнительные
образования:
• 1. трехслойная оболочка:
- Слизистый слой;
- Клеточная стенка;
- Цитоплазматическая
мембрана.
• 2. цитоплазма с
различными включениями
(гранулы крахмала,
гликогена, жира, волютина);
• 3. ядерное вещество
(нуклеоид)
• капсулы,
• споры,
• жгутики,
• пили или фимбрии.
40.
Схематическое изображение строения бактериальной клетки. 1 - оболочка;2 - слизистый слой; 3 - клеточная стенка; 4 - цитоплазматическая
мембрана; 5 - цитоплазма; 6 - рибосома; 7 - полисома; 8 - включения; 9 нуклеоид; 10 - жгутик; 11 - пили
41.
ЖгутикиЭто тонкие нитевидные
фибриллы, состоящие из белка флагеллина. Длина их
значительно превышает длину
бактериальной клетки. Наличие
их можно обнаружить по
определению подвижности клеток
под микроскопом, в полужидкой
питательной среде или при
окраске специальными методами.
По расположению жгутиков бактерии делят на группы (см. рис. ):
монотрихи - с одним жгутиком (возбудитель холеры);
амфитрихи - с пучками или единичными жгутиками на обоих концах клетки
(спириллы);
лофотрихи - с пучком жгутиков на одном конце клетки (фекальный
щелочеобразователь);
перитрихи - жгутики расположены по всей поверхности клетки (кишечные
бактерии).
42.
Спорынаходятся внутри бактериальной
клетки и представляют
уплотненный участок цитоплазмы
с нуклеоидом, одетый собственной
плотной оболочкой.
В бактериальной клетке
образуется только одна спора,
следовательно, споры не являются
органами размножения, а служат
для переживания
неблагоприятных условий.
Споры отличаются по форме, размерам и расположению в клетке. Они
могут располагаться :
центрально (сибирская язва) ,
субтерминально (ближе к концу клетки, возбудитель ботулизма);
терминально (на конце клетки, столбняк)
43.
44.
45.
46. 8.Физиология микроорганизмов, рост, питание и дыхание микроорганизмов.
Физиология изучает жизненные функции микроорганизмов: питание,дыхание, рост и размножение. В основе физиологических функций
лежит непрерывный обмен веществ (метаболизм).
Сущность обмена веществ составляют два противоположных и
вместе с тем взаимосвязанных процесса:
ассимиляция (анаболизм) и диссимиляция (катаболизм).
В процессе ассимиляции происходит усвоение питательных веществ
и использование их для синтеза клеточных структур.
При процессах диссимиляции питательные вещества разлагаются и
окисляются, при этом выделяется энергия, необходимая для жизни
микробной клетки. В результате распада питательных веществ
происходит расщепление сложных органических соединений на
более простые, низкомолекулярные. Часть из них выводится из
клетки, а другие снова используются клеткой для биосинтетических
реакций, и включается в процессы ассимиляции. Все процессы
синтеза и распада питательных веществ совершаются с участием
ферментов.
47. Классификация бактерий по типу питания (усвоение углерода)
Автотрофы(литотрофы)
способны синтезировать сложные
органические вещества из простых
неорганических соединений
(почвенные бактерии
(нитрифицирующие, серобактерии и
др.) ).
Сапрофиты
получают готовые органические
соединения от отмерших организмов. Они
играют важную роль в разложении
мертвых органических остатков,
например бактерии гниения и др.
Гетеротрофы
(органотрофы)
для своего роста и развития
нуждаются в готовых
органических соединениях.
Паразиты
живут и размножаются за счет
органических веществ живой клетки
растений, животных или человека. К
таким микроорганизмам относятся
риккетсии, вирусы и некоторые
простейшие
48. Классификация бактерий по типу питания (усвоение азота)
Аминоавтотрофыдля синтеза белка клетки используют молекулярный
азот воздуха (клубеньковые бактерии, азотобактер) или
усваивают его из аммонийных солей.
Аминогетеротрофы
получают азот из органических соединений - аминокислот,
сложных белков. К ним относят все патогенные микроорганизмы и
большинство сапрофитов.
Классификация бактерий по
источнику энергии
Фототрофы
используют для биосинтетических реакций энергию
солнечного света (пурпурные серобактерии)
Хемотрофы
получают энергию за счет окисления неорганических
веществ (нитрифицирующие бактерии и др.) и
органических соединений (большинство бактерий, в том
числе и патогенные для человека виды)
49. Транспорт питательных веществ. Питательные вещества могут проникать в цитоплазму микробных клеток только в виде небольших
молекул и врастворенном виде.
Питательные вещества проникают в клетку
несколькими способами:
1. Пассивная диффузия
2.Облегченная диффузия
3. Активный транспорт
50. 1. Пассивная диффузия, т.е. перемещение веществ через толщу мембраны, из участка большей концентрации к участку меньшей
концентрации. В результате чеговыравниваются концентрации веществ и осмотическое
давление по обе стороны оболочки.
2.Облегченная диффузия - проникновение питательных
веществ через цитоплазматическую мембрану в клетку по
градиенту его концентрации. Осуществляется с помощью
активного переноса их особыми молекулами переносчиками, называемыми пермеазами. Характерна
высокая скорость переноса веществ.
3. Активный транспорт питательных веществ
осуществляется также с помощью пермеаз
(ферментоподобные белки). Является основным
механизмом избирательного переноса веществ через
цитоплазматическую мембрану в клетку против градиента
концентрации.
51. Дыхание бактерий.
Дыхание (или биологические окисления)микроорганизмов представляет собой совокупность
биохимических процессов, в результате которых
освобождается энергия, необходимая для
жизнедеятельности микробных клеток.
По типу дыхания все микроорганизмы разделяются
на:
1)облигатные (строгие) аэробы,
2)облигатные (строгие) анаэробы ,
3) факультативные (необязательные) анаэробы.
52. 1. Облигатные аэробы (микобактерии туберкулеза и др.) живут и развиваются при свободном доступе кислорода, т. е. реакции
окисления осуществляются уних при участии молекулярного кислорода с
высвобождением большого количества энергии.
C6H12O6 +6O2-6CO2+6H2O+2882, 6кД (688,5ккал)
2. Облигатные анаэробы (клостридии столбняка,
ботулизма и др.) способны жить и размножаться только
в отсутствие свободного кислорода воздуха. Дыхание у
анаэробов происходит путем ферментации субстрата с
образованием небольшого количества энергии.
3. Факультативные анаэробы могут размножаться как
при наличии молекулярного кислорода, так и при
отсутствии его. К ним относят большинство
патогенных и сапрофитных бактерий.
53.
54. Рост и размножение бактерий.
Одним из важнейших проявлений жизнедеятельностимикроорганизмов являются их рост и размножение.
Рост определяется как увеличение размеров отдельной особи
и упорядоченное воспроизведение всех клеточных
компонентов и структур.
Размножение - это способность микроорганизмов к
самовоспроизведению, в результате чего увеличивается число
особей в популяции.
Основной способ размножения у бактерий поперечное
деление.
55.
56.
57. Размножение бактерий на плотных питательных средах.
Бактерии образуют на поверхности среды и внутринеё типичные для каждого микробного вида колонии.
Каждая колония – это популяция микроорганизмов,
развившаяся из одной клетки определенного вида
бактерий.
Колонии бактерий различаются по размеру, форме,
строению, консистенции и цвету. Внешний вид
колоний у некоторых бактерий настолько характерен,
что может служить дифференциальным признаком
для идентификации микроорганизмов.

Биология
Биология








